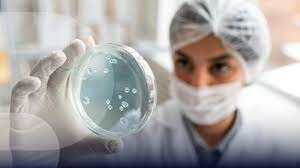
Muchos ensayos clínicos (COVID-19)

-
 El Dr. Edward Jenner descubre que la vacunación con el virus de la viruela vacuna protege a una persona de la infección de la viruela y crea la vacuna contra la viruela. En 1798, publica sus descubrimientos.
El Dr. Edward Jenner descubre que la vacunación con el virus de la viruela vacuna protege a una persona de la infección de la viruela y crea la vacuna contra la viruela. En 1798, publica sus descubrimientos. -
 El Dr. Benjamin Waterhouse vacuna a su hijo y otros familiares contra la viruela. Estas vacunas contra la viruela son las primeras en los EE. UU.
El Dr. Benjamin Waterhouse vacuna a su hijo y otros familiares contra la viruela. Estas vacunas contra la viruela son las primeras en los EE. UU. -
 Massachusetts es el primer estado en exigir que se vacune a los niños contra la viruela antes de ir a la escuela para prevenir el contagio en las instituciones educativas.
Massachusetts es el primer estado en exigir que se vacune a los niños contra la viruela antes de ir a la escuela para prevenir el contagio en las instituciones educativas. -
 El Dr. Louis Pasteur inyecta una serie de vacunas nuevas contra la rabia a un niño al que le mordió un perro con rabia. El niño sobrevive. Esta es la primera vacuna que protege a las persona contra la rabia. Antes de la vacuna antirrábica, casi todas las personas que se infectaban, morían de rabia.
El Dr. Louis Pasteur inyecta una serie de vacunas nuevas contra la rabia a un niño al que le mordió un perro con rabia. El niño sobrevive. Esta es la primera vacuna que protege a las persona contra la rabia. Antes de la vacuna antirrábica, casi todas las personas que se infectaban, morían de rabia. -
 Se autoriza la vacuna contra la tos ferina (pertussis) en los EE. UU.
Se autoriza la vacuna contra la tos ferina (pertussis) en los EE. UU. -
 Hay una pandemia de gripe (influenza). La pandemia de la gripe se produce por una cepa nueva de la gripe, la H1N1. En Nueva York, se solicita a las personas que tienen gripe que se aíslen en su casa. En Chicago, cierran los cines y teatros, y no se permiten las multitudes. En San Francisco, las personas que trabajan de cara al público deben usar mascarillas y se alienta a otros a que también las usen.
Hay una pandemia de gripe (influenza). La pandemia de la gripe se produce por una cepa nueva de la gripe, la H1N1. En Nueva York, se solicita a las personas que tienen gripe que se aíslen en su casa. En Chicago, cierran los cines y teatros, y no se permiten las multitudes. En San Francisco, las personas que trabajan de cara al público deben usar mascarillas y se alienta a otros a que también las usen. -
 Los investigadores estudian los virus de la gripe y desarrollan vacunas contra la gripe. Al comienzo, principalmente los militares pueden vacunarse contra la gripe.
Los investigadores estudian los virus de la gripe y desarrollan vacunas contra la gripe. Al comienzo, principalmente los militares pueden vacunarse contra la gripe. -
 Se aprueban las primeras vacunas contra la gripe que pueden administrarse a personas que no pertenecen al ejército de los EE. UU.
Se aprueban las primeras vacunas contra la gripe que pueden administrarse a personas que no pertenecen al ejército de los EE. UU. -
 En Estados Unidos, la vacuna contra la tos ferina (pertussis), la difteria y el tétanos se combina en una sola vacuna autorizada llamada toxoide diftérico y tetánico y de célula entera de pertussis (o vacuna DTP, por sus siglas en inglés).
En Estados Unidos, la vacuna contra la tos ferina (pertussis), la difteria y el tétanos se combina en una sola vacuna autorizada llamada toxoide diftérico y tetánico y de célula entera de pertussis (o vacuna DTP, por sus siglas en inglés). -
 Entre 1948 y 1955, antes de que hubiera una vacuna disponible contra la poliomielitis, se produjeron varias epidemias de esta enfermedad. Durante este tiempo, muchas personas evitaban las multitudes y encuentros públicos, como ferias, juegos deportivos y piscinas, debido a la preocupación por contagiarse. Algunos padres no permitían que los niños jugaran con amigos nuevos y controlaban con frecuencia la presencia de síntomas.
Entre 1948 y 1955, antes de que hubiera una vacuna disponible contra la poliomielitis, se produjeron varias epidemias de esta enfermedad. Durante este tiempo, muchas personas evitaban las multitudes y encuentros públicos, como ferias, juegos deportivos y piscinas, debido a la preocupación por contagiarse. Algunos padres no permitían que los niños jugaran con amigos nuevos y controlaban con frecuencia la presencia de síntomas. -
 Se informa por primera vez la presencia del virus de Zika en seres humanos.
Se informa por primera vez la presencia del virus de Zika en seres humanos. -
 Una cepa nueva de la gripe, la H2N2, causa otra pandemia. Alrededor de 116 000 personas mueren en los EE. UU. y 1,1 millones en el mundo.
Una cepa nueva de la gripe, la H2N2, causa otra pandemia. Alrededor de 116 000 personas mueren en los EE. UU. y 1,1 millones en el mundo. -
 En respuesta a la pandemia de la gripe que tuvo lugar de 1957 a 1958, el Servicio de Salud Pública de los EE. UU. recomienda las vacunas contra la gripe para personas que tienen un riesgo elevado de sufrir complicaciones por la gripe.
En respuesta a la pandemia de la gripe que tuvo lugar de 1957 a 1958, el Servicio de Salud Pública de los EE. UU. recomienda las vacunas contra la gripe para personas que tienen un riesgo elevado de sufrir complicaciones por la gripe. -
 El Dr. Albert B. Sabin desarrolla una segunda vacuna contra la poliomielitis que recibe autorización en los Estados Unidos. En 1963, se autoriza una tercera vacuna contra esta enfermedad. Estas vacunas ayudan a controlar la trasmisión de la poliomielitis en países industrializados.
El Dr. Albert B. Sabin desarrolla una segunda vacuna contra la poliomielitis que recibe autorización en los Estados Unidos. En 1963, se autoriza una tercera vacuna contra esta enfermedad. Estas vacunas ayudan a controlar la trasmisión de la poliomielitis en países industrializados. -
 Los doctores John F. Enders y Thomas C. Peebles logran aislar el virus del sarampión, llamado la cepa Edmonston, en un tejido. Se usa para desarrollar muchas otras vacunas.
Los doctores John F. Enders y Thomas C. Peebles logran aislar el virus del sarampión, llamado la cepa Edmonston, en un tejido. Se usa para desarrollar muchas otras vacunas. -
 El Dr. Enders y sus colegas elaboran la vacuna atenuada, desarrollada con el virus vivo, contra el sarampión Edmonston B. Esta vacuna y una segunda vacuna obtienen autorización en 1963. Otras dos vacunas atenuadas, elaboradas con el virus vivo, contra el sarampión se autorizan en 1965 y 1968. Durante el siglo XX, se produjeron aproximadamente 500 000 casos anuales de sarampión en los Estados Unidos, mientras que en 2020 hubo 13 casos.
El Dr. Enders y sus colegas elaboran la vacuna atenuada, desarrollada con el virus vivo, contra el sarampión Edmonston B. Esta vacuna y una segunda vacuna obtienen autorización en 1963. Otras dos vacunas atenuadas, elaboradas con el virus vivo, contra el sarampión se autorizan en 1965 y 1968. Durante el siglo XX, se produjeron aproximadamente 500 000 casos anuales de sarampión en los Estados Unidos, mientras que en 2020 hubo 13 casos. -
 La primera vacuna contra las paperas está autorizada por la Administración de Alimentos y Medicamentos (FDA, por sus siglas en inglés) de los Estados Unidos. Las paperas son una causa común de la sordera. Sin embargo, la vacuna contra las paperas hace que la sordera sea menos frecuente. Durante el siglo XX, se produjeron aproximadamente 162 000 casos anuales de paperas en los Estados Unidos, mientras que en 2020 hubo 621 casos.
La primera vacuna contra las paperas está autorizada por la Administración de Alimentos y Medicamentos (FDA, por sus siglas en inglés) de los Estados Unidos. Las paperas son una causa común de la sordera. Sin embargo, la vacuna contra las paperas hace que la sordera sea menos frecuente. Durante el siglo XX, se produjeron aproximadamente 162 000 casos anuales de paperas en los Estados Unidos, mientras que en 2020 hubo 621 casos. -
 Una nueva cepa de la gripe, la H3N2, causa otra pandemia de gripe. Esta pandemia de gripe provoca una cifra aproximada de 100 000 fallecidos en los EE. UU. y alrededor de 1 millón de muertes en todo el mundo. Los investigadores desarrollan vacunas contra la gripe para las cepas específicas que causan la pandemia.
Una nueva cepa de la gripe, la H3N2, causa otra pandemia de gripe. Esta pandemia de gripe provoca una cifra aproximada de 100 000 fallecidos en los EE. UU. y alrededor de 1 millón de muertes en todo el mundo. Los investigadores desarrollan vacunas contra la gripe para las cepas específicas que causan la pandemia. -
 En Fort Dix, un brote de gripe causado por la cepa H1N1 da lugar al desarrollo de un programa de vacunación contra la gripe destinado a prevenir pandemias de esta enfermedad.
En Fort Dix, un brote de gripe causado por la cepa H1N1 da lugar al desarrollo de un programa de vacunación contra la gripe destinado a prevenir pandemias de esta enfermedad. -
 Gracias a las vacunas, la Organización Mundial de la Salud (OMS) declara la erradicación de la viruela en todo el mundo. Finaliza la vacunación contra la viruela. Antes de la vacuna contra la viruela, esta enfermedad se consideró como una de las enfermedades infecciosas más mortales. En el siglo XX, murieron aproximadamente 300 millones de personas de viruela.
Gracias a las vacunas, la Organización Mundial de la Salud (OMS) declara la erradicación de la viruela en todo el mundo. Finaliza la vacunación contra la viruela. Antes de la vacuna contra la viruela, esta enfermedad se consideró como una de las enfermedades infecciosas más mortales. En el siglo XX, murieron aproximadamente 300 millones de personas de viruela. -
 Se autoriza la vacuna contra la difteria, el tétanos y la tos ferina acelular (vacuna DTaP, por sus siglas en inglés). Es una vacuna acelular que casusa menos efectos secundarios que la vacuna DTP de célula entera. La vacuna DTaP termina por sustituir a la vacuna DTP. En 1996, el Comité Asesor sobre Prácticas de Vacunación (ACIP, por sus siglas en inglés) recomienda la vacuna DTaP para los bebés
Se autoriza la vacuna contra la difteria, el tétanos y la tos ferina acelular (vacuna DTaP, por sus siglas en inglés). Es una vacuna acelular que casusa menos efectos secundarios que la vacuna DTP de célula entera. La vacuna DTaP termina por sustituir a la vacuna DTP. En 1996, el Comité Asesor sobre Prácticas de Vacunación (ACIP, por sus siglas en inglés) recomienda la vacuna DTaP para los bebés -
 La vacuna contra la poliomielitis, desarrollada por el Dr. Salk y sus colegas, tiene autorización en los EE. UU. Antes de dicha vacuna, la enfermedad era una causa principal de discapacidad infantil. Durante el siglo XX, se produjeron aproximadamente 16 000 casos anuales de poliomielitis (poliomielitis paralizante) en los Estados Unidos, mientras que en 2020 no hubo ninguno.
La vacuna contra la poliomielitis, desarrollada por el Dr. Salk y sus colegas, tiene autorización en los EE. UU. Antes de dicha vacuna, la enfermedad era una causa principal de discapacidad infantil. Durante el siglo XX, se produjeron aproximadamente 16 000 casos anuales de poliomielitis (poliomielitis paralizante) en los Estados Unidos, mientras que en 2020 no hubo ninguno. -
 La gripe aviar (influenza aviar), causada por la cepa H5N1 de la gripe, infecta a las personas. Esto da lugar al desarrollo de planes de respuesta contra la pandemia de la gripe en los EE. UU. y en todo el mundo.
La gripe aviar (influenza aviar), causada por la cepa H5N1 de la gripe, infecta a las personas. Esto da lugar al desarrollo de planes de respuesta contra la pandemia de la gripe en los EE. UU. y en todo el mundo. -
 En EE. UU., el sarampión se considera erradicado.
En EE. UU., el sarampión se considera erradicado. -
 Se descubre en China el coronavirus del síndrome respiratorio agudo grave (SARS-CoV), que provoca el síndrome respiratorio agudo grave (SARS, por sus siglas en inglés). Desde finales de 2002 hasta finales de 2003, provoca alrededor de 8000 contagios por la enfermedad y 700 muertes. Se propaga a 29 países y, a continuación, desaparece. Los investigadores continúan con el estudio y el desarrollo de vacunas contra el SARS-CoV.
Se descubre en China el coronavirus del síndrome respiratorio agudo grave (SARS-CoV), que provoca el síndrome respiratorio agudo grave (SARS, por sus siglas en inglés). Desde finales de 2002 hasta finales de 2003, provoca alrededor de 8000 contagios por la enfermedad y 700 muertes. Se propaga a 29 países y, a continuación, desaparece. Los investigadores continúan con el estudio y el desarrollo de vacunas contra el SARS-CoV. -
 El ACIP recomienda que los adolescentes reciban una dosis de refuerzo de la vacuna contra el tétanos, la difteria (con baja carga del componente diftérico) y la tos ferina acelular (la vacuna Tdap, por sus siglas en inglés).
El ACIP recomienda que los adolescentes reciban una dosis de refuerzo de la vacuna contra el tétanos, la difteria (con baja carga del componente diftérico) y la tos ferina acelular (la vacuna Tdap, por sus siglas en inglés). -
 Una nueva cepa de la gripe, la H1N1, causa una pandemia. Durante 2009, la gripe provoca alrededor de 61 millones de contagios por la enfermedad, 274 000 hospitalizaciones y 12 400 muertes. Más adelante, en 2009, hay una vacuna disponible contra la cepa H1N1 de la gripe.
Una nueva cepa de la gripe, la H1N1, causa una pandemia. Durante 2009, la gripe provoca alrededor de 61 millones de contagios por la enfermedad, 274 000 hospitalizaciones y 12 400 muertes. Más adelante, en 2009, hay una vacuna disponible contra la cepa H1N1 de la gripe. -
 Se descubre en Arabia Saudita el coronavirus del síndrome respiratorio de Medio Oriente (MERS-CoV), que causa el síndrome respiratorio de Medio Oriente (MERS, por sus siglas en inglés). Provocó aproximadamente 2500 casos y 800 muertes. Muchos investigadores continúan con el estudio y el desarrollo de vacunas contra el MERS-CoV.
Se descubre en Arabia Saudita el coronavirus del síndrome respiratorio de Medio Oriente (MERS-CoV), que causa el síndrome respiratorio de Medio Oriente (MERS, por sus siglas en inglés). Provocó aproximadamente 2500 casos y 800 muertes. Muchos investigadores continúan con el estudio y el desarrollo de vacunas contra el MERS-CoV. -
 La OMS declara que el virus de Zika es una emergencia de salud pública de alcance internacional. Sin embargo, la emergencia de salud pública finaliza más adelante, en 2016. Muchos investigadores estudian y desarrollan de manera activa vacunas contra el virus de Zika. Los investigadores de Mayo Clinic también investigan dichas vacunas. La vacuna contra el virus de Zika tiene una importancia especial porque protege a las personas que tienen un riesgo elevado de padecer complicaciones.
La OMS declara que el virus de Zika es una emergencia de salud pública de alcance internacional. Sin embargo, la emergencia de salud pública finaliza más adelante, en 2016. Muchos investigadores estudian y desarrollan de manera activa vacunas contra el virus de Zika. Los investigadores de Mayo Clinic también investigan dichas vacunas. La vacuna contra el virus de Zika tiene una importancia especial porque protege a las personas que tienen un riesgo elevado de padecer complicaciones. -
 Las vacunas contra la gripe previenen una cifra aproximada de 7,5 millones de contagios por la enfermedad, 3,7 millones de visitas al médico, 105 000 hospitalizaciones y 6300 muertes.
Las vacunas contra la gripe previenen una cifra aproximada de 7,5 millones de contagios por la enfermedad, 3,7 millones de visitas al médico, 105 000 hospitalizaciones y 6300 muertes. -
 Se descubre en China un coronavirus nuevo llamado coronavirus del síndrome respiratorio agudo grave de tipo 2 (SARS-CoV-2). El virus del SARS-CoV-2 causa la enfermedad por coronavirus 2019 (COVID-19). La Organización Mundial de la Salud (OMS) declara en 2020 que el brote de la COVID-19 es una pandemia. La OMS y los Centros para el Control y la Prevención de Enfermedades (CDC, por sus siglas en inglés) emiten recomendaciones para la prevención y el tratamiento de la COVID-19. En enero de 2021
Se descubre en China un coronavirus nuevo llamado coronavirus del síndrome respiratorio agudo grave de tipo 2 (SARS-CoV-2). El virus del SARS-CoV-2 causa la enfermedad por coronavirus 2019 (COVID-19). La Organización Mundial de la Salud (OMS) declara en 2020 que el brote de la COVID-19 es una pandemia. La OMS y los Centros para el Control y la Prevención de Enfermedades (CDC, por sus siglas en inglés) emiten recomendaciones para la prevención y el tratamiento de la COVID-19. En enero de 2021 -
Muchos ensayos clínicos de la vacuna contra la COVID-19 están en curso. Los investigadores utilizan lo que aprendieron previamente de los estudios de la vacuna contra el SARS-CoV, el MERS-CoV y otros virus para desarrollar vacunas que prevengan la COVID-19. Los investigadores también estudian los síntomas de la COVID-19, los efectos a largo plazo, las pruebas diagnósticas, las pruebas de anticuerpos, los tratamientos y los fármacos.
Muchos ensayos clínicos de la vacuna contra la COVID-19 están en curso. Los investigadores utilizan lo que aprendieron previamente de los estudios de la vacuna contra el SARS-CoV, el MERS-CoV y otros virus para desarrollar vacunas que prevengan la COVID-19. Los investigadores también estudian los síntomas de la COVID-19, los efectos a largo plazo, las pruebas diagnósticas, las pruebas de anticuerpos, los tratamientos y los fármacos. -
 La Administración de Alimentos y Medicamentos (FDA, por sus siglas en inglés) autoriza el uso de emergencia de la vacuna contra la COVID-19 de Janssen de Johnson & Johnson. La Administración de Alimentos y Medicamentos (FDA, por sus siglas en inglés) aprueba la vacuna contra la COVID-19 de Pfizer-BioNTech, que ahora se llama Comirnaty, para prevenir la enfermedad en personas de 16 años o más. Asimismo, autoriza la vacuna contra la COVID-19 de Pfizer-BioNTech para niños de 5 a 15 años.
La Administración de Alimentos y Medicamentos (FDA, por sus siglas en inglés) autoriza el uso de emergencia de la vacuna contra la COVID-19 de Janssen de Johnson & Johnson. La Administración de Alimentos y Medicamentos (FDA, por sus siglas en inglés) aprueba la vacuna contra la COVID-19 de Pfizer-BioNTech, que ahora se llama Comirnaty, para prevenir la enfermedad en personas de 16 años o más. Asimismo, autoriza la vacuna contra la COVID-19 de Pfizer-BioNTech para niños de 5 a 15 años. -
 La FDA aprueba la vacuna de Moderna contra la COVID-19, que ahora se llama Spikevax, para evitar que personas mayores de 18 años contraigan la COVID-19. La Administración de Alimentos y Medicamentos (FDA, por sus siglas en inglés) autoriza la administración de la vacuna de Pfizer-BioNTech para niños de 6 meses a 4 años y la vacuna de Moderna para niños de 6 meses a 17 años.
La FDA aprueba la vacuna de Moderna contra la COVID-19, que ahora se llama Spikevax, para evitar que personas mayores de 18 años contraigan la COVID-19. La Administración de Alimentos y Medicamentos (FDA, por sus siglas en inglés) autoriza la administración de la vacuna de Pfizer-BioNTech para niños de 6 meses a 4 años y la vacuna de Moderna para niños de 6 meses a 17 años.
Want to make a timeline like this?
Use Timetoast to turn dates, events, milestones, and phases into a clear visual timeline you can build and share. Timetoast is a timeline maker for work, school, research, and stories.
